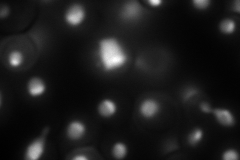
YNL248C
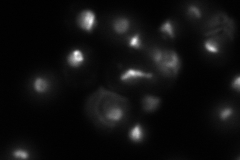
YNL248C
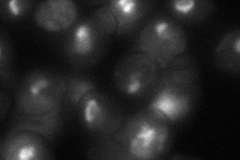
YNL248C
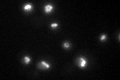
YNL248C

View description
RNA polymerase I subunit A49
Localization:
Intensity:
Fold change:
Significance:
-
C’ GFP library in SD

nucleolus97.24 -
N' NOP1pr-GFP in SD

nucleolus155.113 -
N' TEF2pr-mCherry in SD
nucleus,nucleolus211.35 -
N' NATIVEpr-GFP in SD
nucleolus105.563 -
N' TEF2pr-VC and Cyto-VN in SD
nucleus48.1623 -
C’ GFP library in SD+DTT

nucleolus68.90.7No -
C’ GFP library in SD+H2O2
nucleolus100.991.03No -
C’ GFP library in Starvation Media

nucleolus34.70.35Yes -
C’ GFP library on the background of Pup2-DaMP

nucleolus -
C’ GFP library on the background of CCT mutant

nucleolus104.5691.07526No
